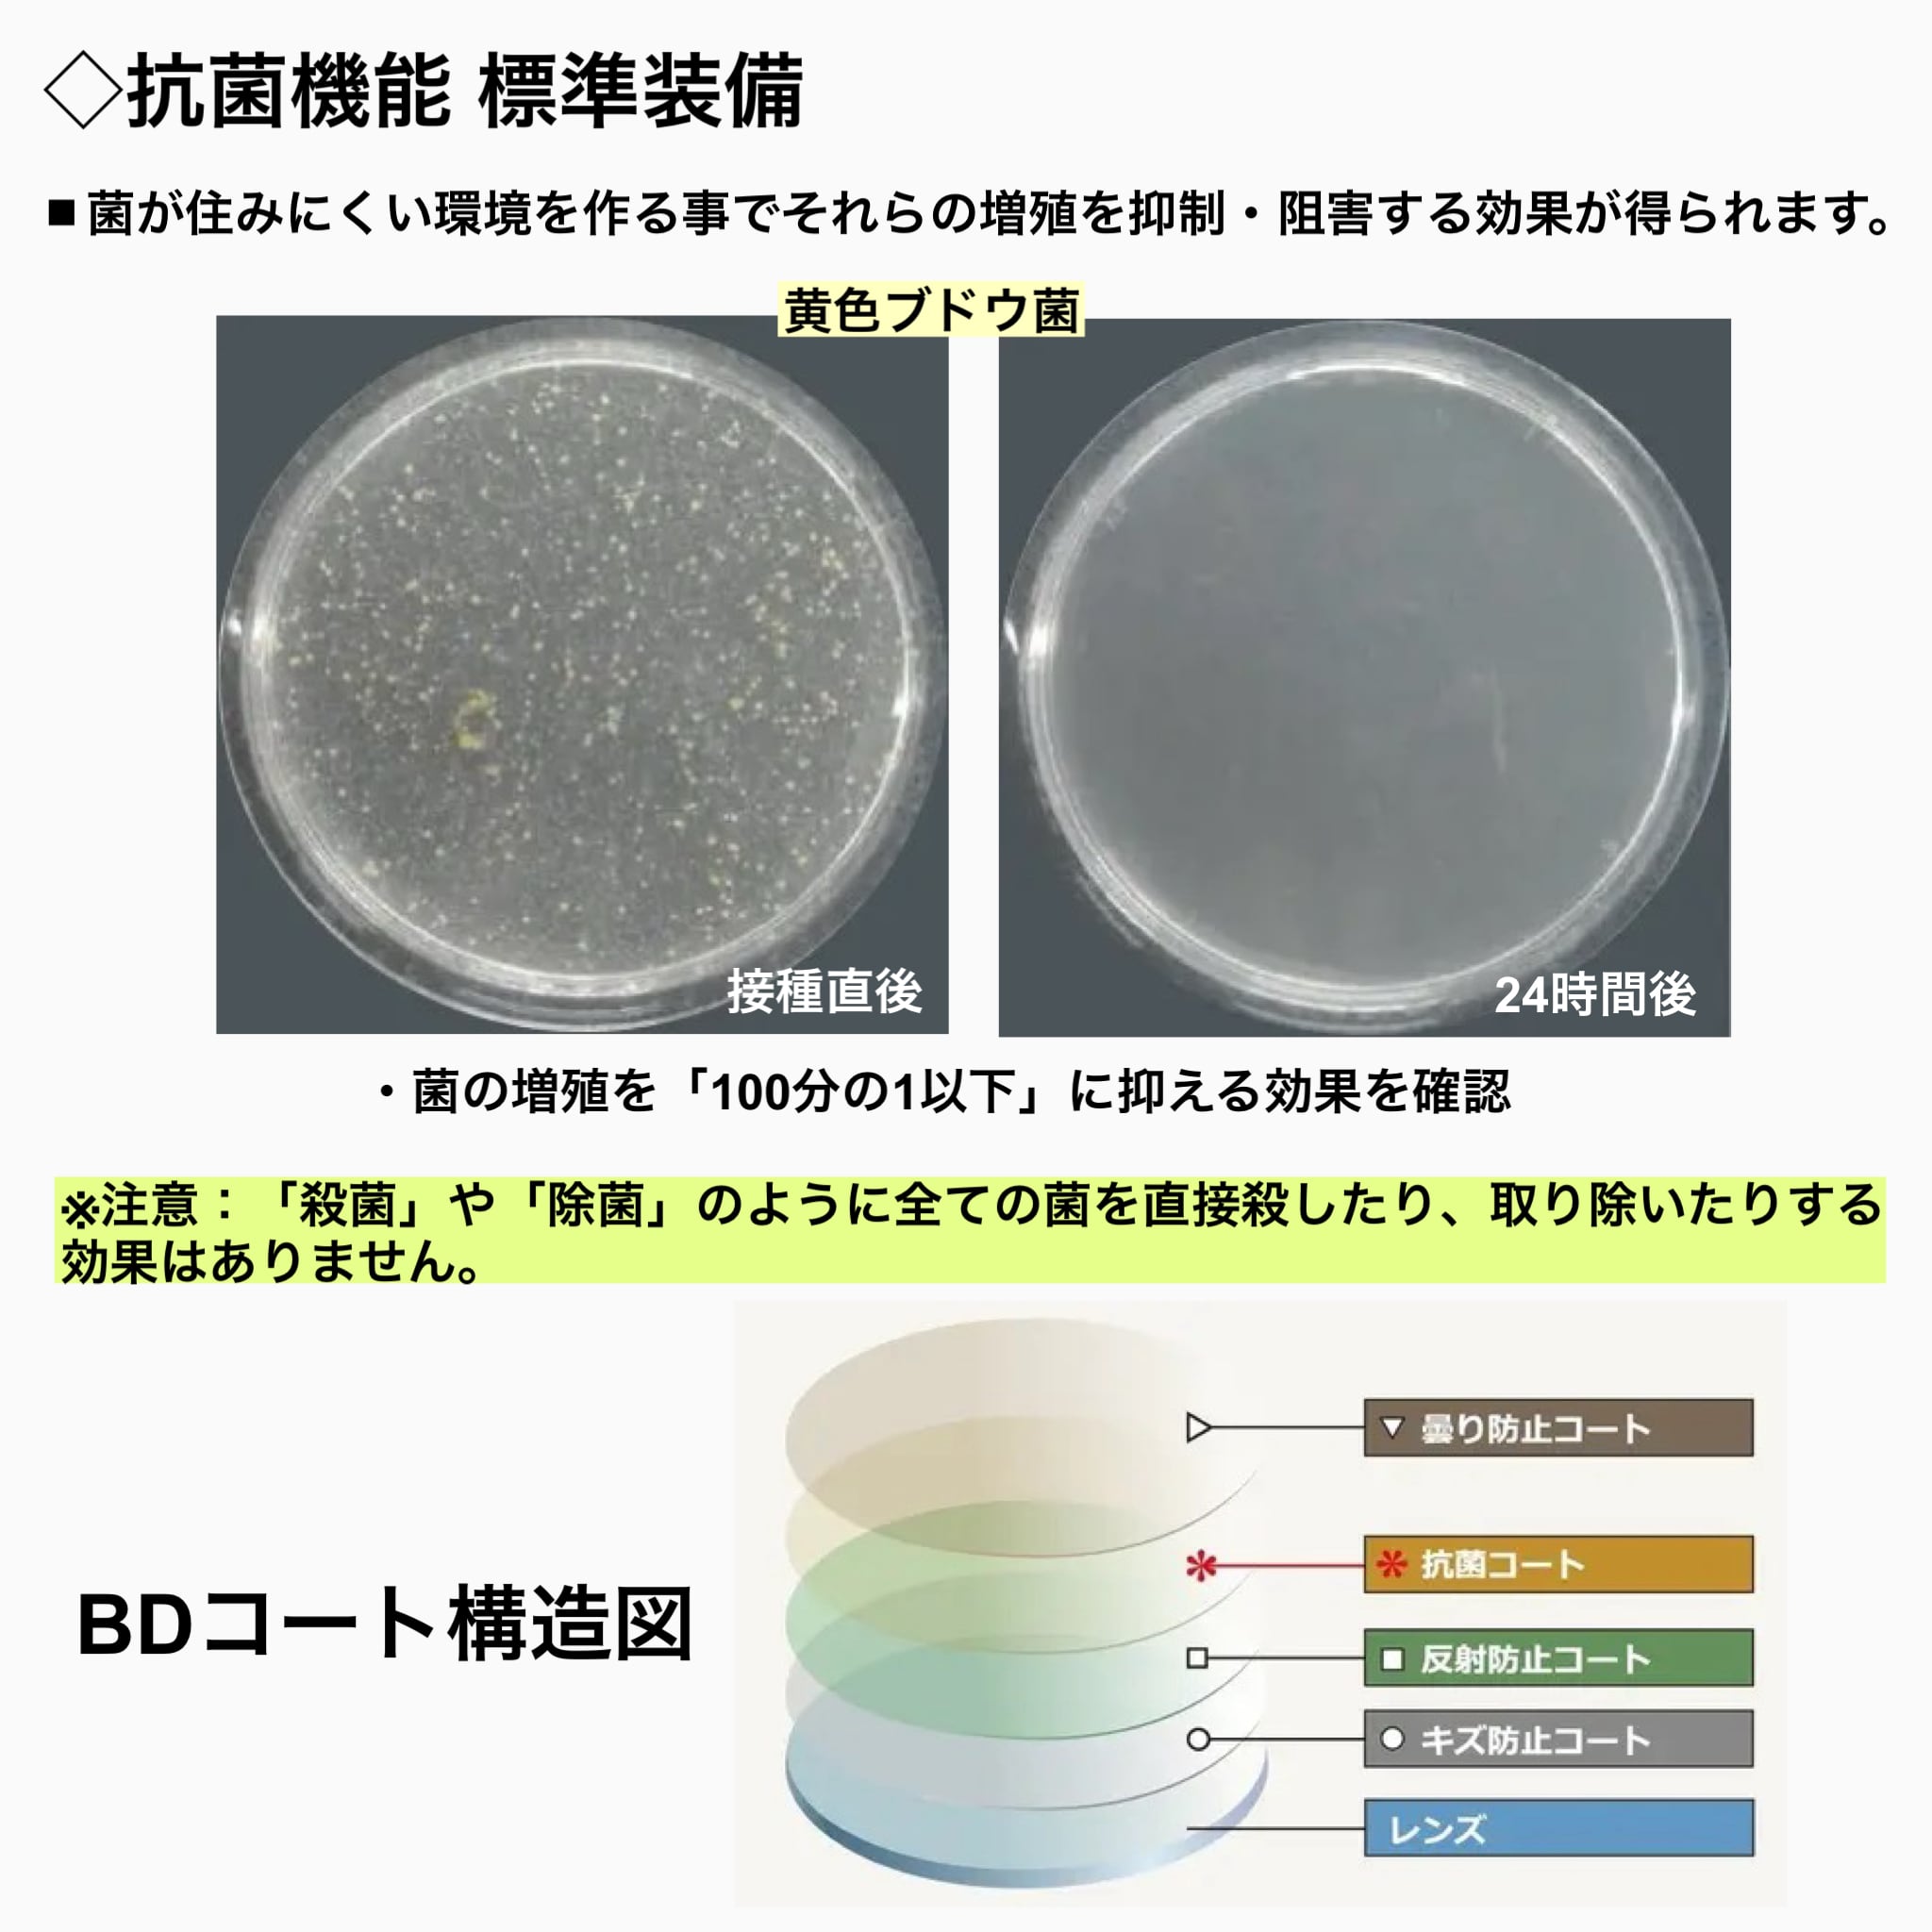

1/13
(レンズ単品)1.60非球面 無色 2枚1組 イトーレンズ エルム160AS BDコート 曇りにくい 防曇レンズ UVカット 度付き対応 メガネレンズ交換 持ち込み可
¥11,300 税込
この商品は送料無料です。
【曇りにくくて快適!キズにも強い防曇レンズ】
マスク使用時や寒暖差のある場所でも視界クリア!くもりに強い「BDコート」を施した1.60非球面プラスチックレンズ。
専用メガネ拭き付きでお手入れ簡単。
毎日使うメガネに最適な高機能レンズです。
◆BDコートとは?
BDコートは「水分を膜状に広げてなじませる」親水性コーティング。
従来の撥水コートとは逆の発想で、蒸気や湿気によるレンズの曇りを防止します。
さらに、抗菌機能も搭載し、衛生面にも配慮されています。
◆ご使用シーン例
・マスク着用時(ウイルス・花粉症対策)
・ラーメンや鍋などの食事中
・冬の屋外から暖房の効いた室内へ入るとき
・梅雨や真夏の湿気が多い時期
◆スペック
レンズタイプ:1.60非球面プラスチックレンズ
コート:BD(防曇)コート/ハードマルチコート
屈折率:1.60
アッベ数:41
比重:1.31
UV加工:UV練り込み済み
対応度数:中度〜やや強度(−2.00〜−4.00程度の方に最適)
※注意事項:本商品は「曇らないレンズ」ではなく「曇りにくいレンズ」です。防曇効果は使用環境により異なります。
※納期:受注生産のため発送まで7〜10日程度いただきます。
-
レビュー
(3)
-
送料・配送方法について
-
お支払い方法について
¥11,300 税込
送料無料
最近チェックした商品
同じカテゴリの商品
その他の商品
CATEGORY